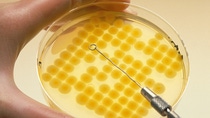

Who we are
Bread, Vitamins and Water – BASF Nourishes the World
According to UN estimates, the world’s population will grow to around nine billion people by 2050. They need food – in sufficient quantity and high quality. Humanity faces a similar situation around 1900. BASF makes an essential contribution in solving the problem.
Around 1900 and today: with the world population growing rapidly, conventional farming practices reach their limits in providing food to all people. In the first place, there is not enough nitrogen fertilizer for agriculture. BASF joins the search for a synthetic nitrogen compound – and succeeds: in 1913, BASF starts producing synthetic ammonia as a basis for mineral fertilizers.
After 1945, BASF starts tackling weeds and pests and in 1949 it produces the herbicide U46, its first of what is today a broad range of crop protection agents. BASF’s product range is supplemented by consultation on the effective and safe use of crop protection agents and fertilizers at agricultural information centers all over the world.
BASF’s ingredients are not only used in cultivation, but also put into baking agents (1915), carbonic acid (1917) or vitamins (1970).
In addition to the production of food, the supply of drinking water is also a key issue. In sea water desalination plants and thus in the production of drinking water, plastics produced by BASF play a significant role.